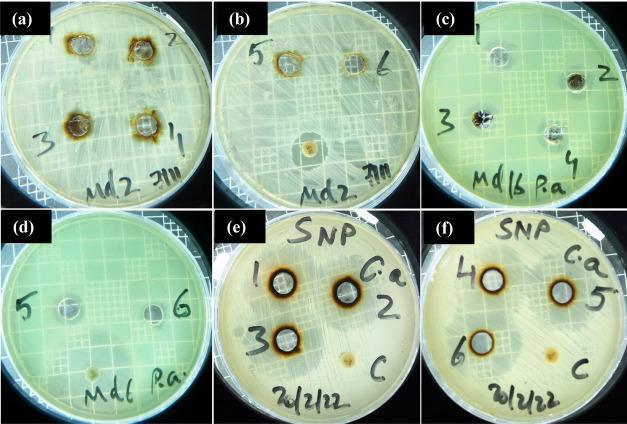
https://cdn.ncbi.nlm.nih.gov/pmc/blobs/c769/10233848/62337d69bb99/ao3c01292_0010.jpg

利用植物皮层提取物绿色合成银纳米颗粒用于高效去除废水中的罗丹明B阳离子染料及抗菌活性评估
Green Synthesis of Silver Nanoparticles Using Plant Cortex Extract for Efficient Removal of Rhodamine B Cationic Dye from Wastewater and the Evaluation of Antimicrobial Activity.
作者信息
Alamier Waleed M, D Y Oteef Mohammed, Bakry Ayyob M, Hasan Nazim, Ismail Khatib Sayeed, Awad Fathi S
机构信息
Department of Chemistry, Faculty of Science, Jazan University, Jazan 45142, Saudi Arabia.
Department of Biology, Faculty of Science, Jazan University, Jazan 45142, Saudi Arabia.
出版信息
ACS Omega. 2023 May 15;8(21):18901-18914. doi: 10.1021/acsomega.3c01292. eCollection 2023 May 30.
Silver nanoparticles (Ag-NPs) exhibit vast potential in numerous applications, such as wastewater treatment and catalysis. In this study, we report the green synthesis of Ag-NPs using plant cortex extract to reduce cationic Rhodamine B (RhB) dye and for antibacterial and antifungal applications. The green synthesis of Ag-NPs involves three main phases: activation, growth, and termination. The shape and morphologies of the prepared Ag-NPs were studied through different analytical techniques. The results confirmed the successful preparation of Ag-NPs with a particle size distribution ranging from 1 to 40 nm. The Ag-NPs were used as a heterogeneous catalyst to reduce RhB dye from aqueous solutions in the presence of sodium borohydride (NaBH). The results showed that 96% of catalytic reduction can be accomplished within 32 min using 20 μL of 0.05% Ag-NPs aqueous suspension in 100 μL of 1 mM RhB solution, 2 mL of deionized water, and 1 mL of 10 mM NaBH solution. The results followed a zero-order chemical kinetic ( = 0.98) with reaction rate constant as 0.059 mol L s. Furthermore, the Ag-NPs were used as antibacterial and antifungal agents against 16 Gram-positive and Gram-negative bacteria as well as 1 fungus. The green synthesis of Ag-NPs is environmentally friendly and inexpensive, as well as yields highly stabilized nanoparticles by phytochemicals. The substantial results of catalytic reductions and antimicrobial activity reflect the novelty of the prepared Ag-NPs. These nanoparticles entrench the dye and effectively remove the microorganisms from polluted water.
银纳米颗粒(Ag-NPs)在众多应用中展现出巨大潜力,如废水处理和催化。在本研究中,我们报道了利用植物皮层提取物绿色合成Ag-NPs,用于还原阳离子罗丹明B(RhB)染料以及抗菌和抗真菌应用。Ag-NPs的绿色合成涉及三个主要阶段:活化、生长和终止。通过不同分析技术研究了制备的Ag-NPs的形状和形态。结果证实成功制备了粒径分布在1至40nm的Ag-NPs。将Ag-NPs用作多相催化剂,在硼氢化钠(NaBH)存在下从水溶液中还原RhB染料。结果表明,在100μL 1mM RhB溶液、2mL去离子水和1mL 10mM NaBH溶液中,使用20μL 0.05% Ag-NPs水悬浮液,32分钟内可实现96%的催化还原。结果符合零级化学动力学( = 0.98),反应速率常数 为0.059 mol L s。此外,Ag-NPs用作针对16种革兰氏阳性和革兰氏阴性细菌以及1种真菌的抗菌和抗真菌剂。Ag-NPs的绿色合成环境友好且成本低廉,同时植物化学物质可产生高度稳定的纳米颗粒。催化还原和抗菌活性的显著结果反映了所制备Ag-NPs的新颖性。这些纳米颗粒能固定染料并有效从污染水中去除微生物。